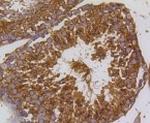
PIK3R3 Antibody in Immunohistochemistry (Paraffin) (IHC (P))

Search
Abnova
PIK3R3 Recombinant Rabbit Monoclonal Antibody
{{$productOrderCtrl.translations['antibody.pdp.commerceCard.promotion.promotions']}}
{{$productOrderCtrl.translations['antibody.pdp.commerceCard.promotion.viewpromo']}}
{{$productOrderCtrl.translations['antibody.pdp.commerceCard.promotion.promocode']}}: {{promo.promoCode}} {{promo.promoTitle}} {{promo.promoDescription}}. {{$productOrderCtrl.translations['antibody.pdp.commerceCard.promotion.learnmore']}}

Please note: We are reviewing Western blot images included in the antibody testing data in our catalog, including those provided by third parties. Unless expressly labeled or annotated as “raw-unedited”, Western blot images included in the antibody testing data in our catalog may have been edited, optimized or otherwise adjusted for presentation.
产品信息
RAB02696
种属反应
宿主/亚型
Expression System
分类
类型
偶联物
形式
纯化类型
保存液
内含物
保存条件
运输条件
靶标信息
PIK3R3 binds to activated (phosphorylated) protein-tyrosine kinases through its SH2 domain and regulates their kinase activity. During insulin stimulation, it also binds to IRS-1. It is a component of a heterodimer of p110 (catalytic) and p55 (regulatory) subunits. The protein is expressed at highest levels in brain and testis. Lower levels are detected in adipose tissue, kidney, heart, lung and skeletal muscle. The protein contains 2 SH2 domains.
仅用于科研。不用于诊断过程。未经明确授权不得转售。
篇参考文献 (0)
生物信息学
蛋白别名: p55PIK; phosphatidylinositol 3 kinase, regulatory subunit, polypeptide 3 (p55); Phosphatidylinositol 3-kinase 55 kDa regulatory subunit gamma; phosphatidylinositol 3-kinase p55 subunit; Phosphatidylinositol 3-kinase regulatory subunit gamma; PI3-kinase p85 subunit gamma; PI3-kinase regulatory subunit gamma; PI3-kinase subunit p55-gamma; PI3K regulatory subunit gamma; ptdIns-3-kinase p85-gamma; ptdIns-3-kinase regulatory subunit gamma; ptdIns-3-kinase regulatory subunit p55-gamma; RP4-533D7.2
基因别名: AA414954; p55pik; PIK3R3
UniProt ID: (Rat) Q63789, (Mouse) Q64143
Entrez Gene ID: (Rat) 60664, (Mouse) 18710



